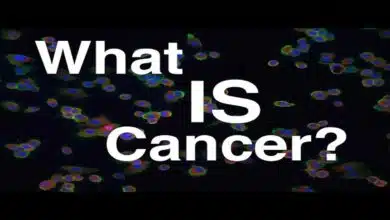
Cancer: Causes, Symptoms, Diagnosis, Treatment

Cancer के सबसे बड़े जोखिम: क्यों अब अर्ली डिटेक्शन जरूरी है?
भारत में कैंसर की घटनाएं 1990 से 2023 तक प्रति लाख पर 84.8 से 107.2 हो गईं, जबकि मृत्यु दर 71.7 से 86.9 पहुंची। 2026 तक नए मामलों की संख्या 15 लाख से ऊपर रहने का अनुमान है, और 2045 तक 24.5 लाख तक पहुंच सकती है।

Cancer आज दुनिया भर में मौत का दूसरा सबसे बड़ा कारण बन चुका है, और भारत में भी इसके मामले तेजी से बढ़ रहे हैं। 2023 में भारत में 15 लाख नए मामले दर्ज हुए, जो 2050 तक दोगुने से अधिक हो सकते हैं, इसलिए जोखिम कारकों को समझना और प्रारंभिक जांच कराना जीवन रक्षक साबित हो सकता है।
विषय सूची
Cancer क्या है?
कैंसर कोशिकाओं के अनियंत्रित विकास की बीमारी है, जो शरीर के किसी भी अंग को प्रभावित कर सकती है। यह सामान्य कोशिकाओं के डीएनए में उत्परिवर्तन से शुरू होता है, जो वंशानुगत या पर्यावरणीय कारकों से होता है। भारत जैसे विकासशील देशों में जीवनशैली परिवर्तन के कारण कैंसर के मामले बढ़ रहे हैं, जहां 65% मरीज निदान के बाद भी जान गंवा देते हैं।
भारत में Cancer का बढ़ता संकट
भारत में कैंसर की घटनाएं 1990 से 2023 तक प्रति लाख पर 84.8 से 107.2 हो गईं, जबकि मृत्यु दर 71.7 से 86.9 पहुंची। 2026 तक नए मामलों की संख्या 15 लाख से ऊपर रहने का अनुमान है, और 2045 तक 24.5 लाख तक पहुंच सकती है। प्रमुख कारणों में तंबाकू, प्रदूषण और देरी से निदान शामिल हैं, जो वैश्विक औसत से अधिक घातक साबित हो रहे हैं।
यह भी पढ़ें: Stomach Cancer के शुरुआती लक्षण: समय रहते पहचानें और जीवन बचाएं

Cancer के सबसे बड़े जोखिम कारक
धूम्रपान और तंबाकू
धूम्रपान फेफड़े, मुंह और गले के कैंसर का 90% कारण है। भारत में तंबाकू से 13 लाख मौतें सालाना होती हैं। गुटखा और सिगरेट जैसे उत्पाद डीएनए को नुकसान पहुंचाते हैं।
अस्वास्थ्यकर आहार और मोटापा
प्रोसेस्ड फूड, अधिक चीनी और वसा से कोलोरेक्टल तथा ब्रेस्ट कैंसर का खतरा 30-50% बढ़ता है। मोटापा हार्मोन असंतुलन पैदा करता है।
शराब का अत्यधिक सेवन
शराब लीवर, ब्रेस्ट और एसोफेजियल कैंसर को बढ़ावा देती है। रोजाना 2 से अधिक ड्रिंक से जोखिम दोगुना हो जाता है।
प्रदूषण और पर्यावरणीय खतरे
वायु प्रदूषण फेफड़े के कैंसर का बड़ा कारण है, खासकर दिल्ली जैसे शहरों में। एस्बेस्टस और रसायन व्यावसायिक जोखिम बढ़ाते हैं।
संक्रमण और वायरस
एचपीवी से सर्वाइकल कैंसर, हेपेटाइटिस बी से लीवर कैंसर होता है। भारत में 50% लीवर कैंसर संक्रमण से जुड़े हैं।
आनुवंशिक और उम्र संबंधी कारक
केवल 5-10% कैंसर वंशानुगत होते हैं, लेकिन 50 वर्ष से ऊपर उम्र जोखिम दोगुनी कर देती है।
| जोखिम कारक | प्रभावित कैंसर | रोकथाम का तरीका |
| धूम्रपान | फेफड़े, मुंह | छोड़ दें |
| मोटापा | ब्रेस्ट, कोलोरेक्टल | स्वस्थ आहार |
| प्रदूषण | फेफड़े | मास्क, स्वच्छता |
| संक्रमण | सर्वाइकल, लीवर | वैक्सीन |

प्रमुख Cancer प्रकार और उनके लक्षण
भारत में ब्रेस्ट, फेफड़े, मुंह, सर्वाइकल और कोलोरेक्टल कैंसर सबसे आम हैं।
ब्रेस्ट कैंसर
महिलाओं में सबसे ज्यादा, गांठ, निप्पल से डिस्चार्ज लक्षण। शुरुआती चरण में 99% सर्वाइवल।
फेफड़े का कैंसर
धूम्रपान से जुड़ा, खांसी, सांस फूलना। भारत में पुरुषों में प्रमुख।
सर्वाइकल कैंसर
एचपीवी से, असामान्य ब्लीडिंग। वैक्सीन से रोकथाम संभव।
मुंह का कैंसर
तंबाकू से, अल्सर जो न ठीक हो। भारत में सबसे ज्यादा मामले।
अन्य: प्रोस्टेट, थायरॉइड, ब्लड कैंसर।
यह भी पढ़ें: Cancer: कारण, लक्षण, निदान, उपचार और बचाव की पूरी जानकारी
अर्ली डिटेक्शन क्यों महत्वपूर्ण?
अर्ली डिटेक्शन से 90% मामलों में इलाज संभव है, जबकि देरी से 65% मरीज मर जाते हैं। स्क्रीनिंग से कैंसर स्टेज 1 में पकड़ा जाता है, जहां सर्वाइवल 80-90% होती है। भारत में देरी से निदान मुख्य समस्या है।
स्क्रीनिंग विधियां
- मैमोग्राम: ब्रेस्ट (40+ महिलाएं)
- पॅप स्मीयर: सर्वाइकल
- कोलोनोस्कोपी: कोलोरेक्टल
- लो-डोज CT: फेफड़े (धूम्रपानियों के लिए)
- PSA टेस्ट: प्रोस्टेट
नई तकनीक: मल्टी-कैंसर अर्ली डिटेक्शन (MCED) ब्लड टेस्ट, एक टेस्ट से दर्जनों कैंसर का पता।
| कैंसर प्रकार | स्क्रीनिंग टेस्ट | उम्र/आवृत्ति |
| ब्रेस्ट | मैमोग्राम | 40+ सालाना |
| सर्वाइकल | पॅप स्मीयर | 30-65 हर 3 साल |
| कोलोरेक्टल | कोलोनोस्कोपी | 45+ हर 10 साल |

Cancer रोकथाम के व्यावहारिक उपाय
40% कैंसर जीवनशैली से रोके जा सकते हैं।
- तंबाकू छोड़ें: जोखिम 50% कम।
- स्वस्थ आहार: फल-सब्जी 5 सर्विंग रोज।
- व्यायाम: हफ्ते में 150 मिनट।
- वैक्सीन: एचपीवी, हेपेटाइटिस।
- सूरज से सुरक्षा: UV कैंसर से बचाव।
उपचार विकल्प
- सर्जरी: ट्यूमर हटाना।
- कीमोथेरेपी: कोशिकाएं नष्ट।
- रेडिएशन: विकिरण से।
- इम्यूनोथेरेपी: शरीर की रक्षा प्रणाली मजबूत।
- टार्गेटेड थेरेपी: विशिष्ट जीन पर।
नोट: अर्ली स्टेज में सर्जरी पर्याप्त।
सरकारी योजनाएं और सहायता
आयुष्मान भारत: 5 लाख तक मुफ्त इलाज। राष्ट्रीय कैंसर नियंत्रण कार्यक्रम: मुफ्त स्क्रीनिंग शिविर। ICMR स्टडीज जागरूकता बढ़ा रही हैं।
सामान्य मिथक और तथ्य
- मिथक: कैंसर संक्रामक। तथ्य: ज्यादातर नहीं।
- मिथक: चीनी कैंसर बढ़ाती है। तथ्य: मोटापा बढ़ाता है।
- मिथक: केवल बुजुर्गों को होता है। तथ्य: युवाओं में भी।
निष्कर्ष:
अर्ली डिटेक्शन से कैंसर हराया जा सकता है। नियमित जांच, स्वस्थ जीवनशैली अपनाएं। जागरूकता अभियानों में भाग लें।

Cancer के इन जोखिमों से बचाव के घरेलू उपाय
कैंसर के जोखिमों से बचाव के लिए घरेलू उपाय जीवनशैली में सरल बदलावों से संभव हैं, जो इम्यूनिटी बढ़ाते हैं और विषाक्त पदार्थों से बचाते हैं। ये उपाय चिकित्सा जांच के पूरक हैं, न कि विकल्प।
आहार संबंधी घरेलू उपाय
हल्दी वाला दूध प्रतिदिन पिएं, क्योंकि इसमें करक्यूमिन सूजन कम करता है और कोशिकाओं की रक्षा करता है। ग्रीन टी या नींबू पानी एंटीऑक्सीडेंट्स प्रदान करते हैं, जो फ्री रेडिकल्स से लड़ते हैं।
- हरी सब्जियां जैसे पालक, ब्रोकली रोजाना खाएं; ये कैंसर-रोधी यौगिकों से भरपूर हैं।
- लहसुन की 1-2 कलियां कच्ची चबाएं; यह सल्फर कंपाउंड्स से डिटॉक्स करता है।
- आंवला या एलोवेरा जूस सुबह लें; विटामिन सी कोशिकाओं की मरम्मत करता है।
जीवनशैली बदलाव
धूम्रपान और तंबाकू पूरी तरह छोड़ें, क्योंकि ये 30% कैंसर का कारण हैं। शराब सीमित रखें या न पिएं।
नियमित व्यायाम जैसे योग या वॉक हफ्ते में 150 मिनट करें; यह मोटापा कम कर जोखिम घटाता है। तनाव प्रबंधन के लिए ध्यान या प्राणायाम अपनाएं।
| जोखिम कारक | घरेलू बचाव उपाय | लाभ |
| धूम्रपान | तंबाकू त्यागें | फेफड़े की रक्षा |
| मोटापा | योग + साबुत अनाज | हार्मोन संतुलन |
| प्रदूषण | ग्रीन टी + मास्क | डिटॉक्स |
| कमजोर इम्यूनिटी | तुलसी-गिलोय काढ़ा | रोग प्रतिरोध |
इम्यूनिटी बूस्टर नुस्खे
तुलसी और गिलोय का काढ़ा बनाकर पिएं; ये विषाणुओं से लड़ते हैं। सोंठ का चूर्ण आधा चम्मच सुबह-शाम लें।
ये उपाय 40% कैंसर के जोखिम को कम कर सकते हैं, लेकिन डॉक्टर से सलाह लें और नियमित स्क्रीनिंग कराएं।
अस्वीकरण: यह जानकारी केवल सामान्य जानकारी के लिए है और इसे किसी चिकित्सकीय सलाह के रूप में नहीं लिया जाना चाहिए। किसी भी स्वास्थ्य समस्या के लिए हमेशा अपने डॉक्टर से सलाह लें।
अन्य खबरों के लिए यहां क्लिक करें